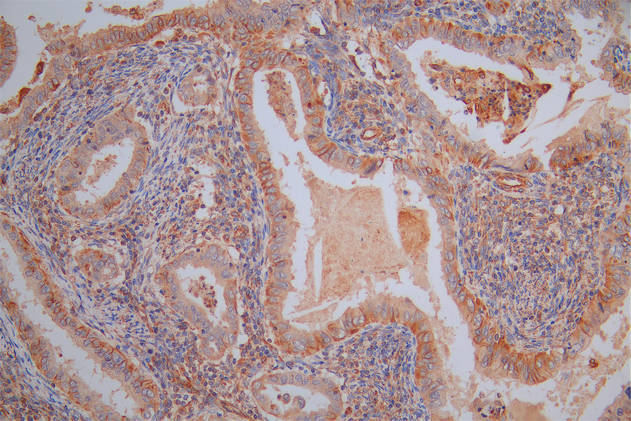

-
中文名稱:EGFR兔多克隆抗體
-
貨號:CSB-PA007479GA01HU
-
規格:¥3,900
-
其他:
產品詳情
-
Uniprot No.:
-
基因名:
-
別名:Avian erythroblastic leukemia viral (v erb b) oncogene homolog antibody; Cell growth inhibiting protein 40 antibody; Cell proliferation inducing protein 61 antibody; EGF R antibody; EGFR antibody; EGFR_HUMAN antibody; Epidermal growth factor receptor (avian erythroblastic leukemia viral (v erb b) oncogene homolog) antibody; Epidermal growth factor receptor (erythroblastic leukemia viral (v erb b) oncogene homolog avian) antibody; Epidermal growth factor receptor antibody; erb-b2 receptor tyrosine kinase 1 antibody; ERBB antibody; ERBB1 antibody; Errp antibody; HER1 antibody; mENA antibody; NISBD2 antibody; Oncogen ERBB antibody; PIG61 antibody; Proto-oncogene c-ErbB-1 antibody; Receptor tyrosine protein kinase ErbB 1 antibody; Receptor tyrosine-protein kinase ErbB-1 antibody; SA7 antibody; Species antigen 7 antibody; Urogastrone antibody; v-erb-b Avian erythroblastic leukemia viral oncogen homolog antibody; wa2 antibody; Wa5 antibody
-
宿主:Rabbit
-
反應種屬:Human
-
免疫原:Human EGFR
-
免疫原種屬:Homo sapiens (Human)
-
抗體亞型:IgG
-
純化方式:Antigen Affinity Purified
-
濃度:It differs from different batches. Please contact us to confirm it.
-
保存緩沖液:PBS with 0.02% Sodium Azide, 50% Glycerol, pH 7.3. -20°C, Avoid freeze / thaw cycles.
-
產品提供形式:Liquid
-
應用范圍:ELISA,WB
-
Protocols:
-
儲存條件:Upon receipt, store at -20°C or -80°C. Avoid repeated freeze.
-
貨期:Basically, we can dispatch the products out in 1-3 working days after receiving your orders. Delivery time maybe differs from different purchasing way or location, please kindly consult your local distributors for specific delivery time.
-
用途:For Research Use Only. Not for use in diagnostic or therapeutic procedures.
引用文獻
- EGFR expression in circulating tumor cells from high-grade Metastatic Sarcomas Braun AC.et al,Cancer Biol Ther,2018
相關產品
靶點詳情
-
功能:Receptor tyrosine kinase binding ligands of the EGF family and activating several signaling cascades to convert extracellular cues into appropriate cellular responses. Known ligands include EGF, TGFA/TGF-alpha, AREG, epigen/EPGN, BTC/betacellulin, epiregulin/EREG and HBEGF/heparin-binding EGF. Ligand binding triggers receptor homo- and/or heterodimerization and autophosphorylation on key cytoplasmic residues. The phosphorylated receptor recruits adapter proteins like GRB2 which in turn activates complex downstream signaling cascades. Activates at least 4 major downstream signaling cascades including the RAS-RAF-MEK-ERK, PI3 kinase-AKT, PLCgamma-PKC and STATs modules. May also activate the NF-kappa-B signaling cascade. Also directly phosphorylates other proteins like RGS16, activating its GTPase activity and probably coupling the EGF receptor signaling to the G protein-coupled receptor signaling. Also phosphorylates MUC1 and increases its interaction with SRC and CTNNB1/beta-catenin. Positively regulates cell migration via interaction with CCDC88A/GIV which retains EGFR at the cell membrane following ligand stimulation, promoting EGFR signaling which triggers cell migration. Plays a role in enhancing learning and memory performance.; Isoform 2 may act as an antagonist of EGF action.; (Microbial infection) Acts as a receptor for hepatitis C virus (HCV) in hepatocytes and facilitates its cell entry. Mediates HCV entry by promoting the formation of the CD81-CLDN1 receptor complexes that are essential for HCV entry and by enhancing membrane fusion of cells expressing HCV envelope glycoproteins.
-
基因功能參考文獻:
- Amphiregulin contained in non-small-cell lung carcinoma-derived exosomes induces osteoclast differentiation through the activation of EGFR pathway. PMID: 28600504
- Combine vorinostat with an EGFRTKI to reverse EGFRTKI resistance in NSCLC. PMID: 30365122
- The feasibility of using the radiocobalt labeled antiEGFR affibody conjugate ZEGFR:2377 as an imaging agent. PMID: 30320363
- In comparison of all transfection complexes, 454 lipopolyplexes modified with the bidentate PEG-GE11 agent show the best, EGFR-dependent uptake as well as luciferase and NIS gene expression into PMID: 28877405
- EGFR amplification was higher in the OSCC group than in the control group (P=0.018) and was associated with advanced clinical stage (P=0.013), regardless of age. Patients with EGFR overexpression had worse survival rates, as did patients who had T3-T4 tumours and positive margins. EGFR overexpression has a negative impact on disease progression. PMID: 29395668
- Clonal analysis shows that the dominant JAK2 V617F-positive clone in Polycythemia Vera harbors EGFR C329R substitution, thus this mutation may contribute to clonal expansion. PMID: 28550306
- Baseline Circulating tumor cell count could be a predictive biomarker for EGFR-mutated and ALK-rearranged non-small cell lung cancer , which allows for better guidance and monitoring of patients over the course of molecular targeted therapies. PMID: 29582563
- High EGFR expression is associated with cystic fibrosis. PMID: 29351448
- these results suggest a mechanism for EGFR inhibition to suppress respiratory syncytial virus by activation of endogenous epithelial antiviral defenses PMID: 29411775
- This study detected the emergence of T790M mutation within the EGFR cDNA in a subset of erlotinib resistant PC9 cell models through Sanger sequencing and droplet digital PCR-based methods, demonstrating that T790M mutation can emerge via de novo events following treatment with erlotinib. PMID: 29909007
- the present study demonstrated that miR145 regulates the EGFR/PI3K/AKT signaling pathway in patients with nonsmall cell lung cancer. PMID: 30226581
- among NSCLC patients treated with EGFR-TKI, those with T790M mutations were found to frequently also show 19 dels, compared to T790M-negative patients. In addition, T790M-positive patients had a longer PFS. Therefore, screening these patients for T790M mutations may help in improving survival. PMID: 30150444
- High EGFR expression is associated with Breast Carcinoma. PMID: 30139236
- results showed that CAV-1 could promote anchorage-independent growth and anoikis resistance in detached SGC-7901 cells, which was associated with the activation of Src-dependent epidermal growth factor receptor-integrin beta signaling as well as the phosphorylation of PI3K/Akt and MEK/ERK signaling pathways PMID: 30088837
- our results indicate that FOXK2 inhibits the malignant phenotype of clear-cell renal cell carcinoma and acts as a tumor suppressor possibly through the inhibition of EGFR. PMID: 29368368
- EGFR mutation status in advanced non-small cell lung cancer (NSCLC) patients altered significantly PMID: 30454543
- Different Signaling Pathways in Regulating PD-L1 Expression in EGFR Mutated Lung Adenocarcinoma PMID: 30454551
- internal tandem duplication of kinase domain delineates a genetic subgroup of congenital mesoblastic nephroma transcending histological subtypes PMID: 29915264
- The expression level of EGFR increased along with higher stages and pathologic grades of BTCC, and the obviously increased expression of HER-2 was statistically associated with clinical stages and tumor recurrence. In addition, the expression level of HER-2 increased along with the higher clinical stage of BTCC. EGFR expression and HER-2 levels were positively associated in BTCC samples. PMID: 30296252
- Results show that GGA2 interacts with EGFR cytoplasmic domain to stabilize its expression and reducing its lysosomal degradation. PMID: 29358589
- combination therapy of apatinib with icotinib for primary acquired resistance to icotinib may be an option for patients with advanced pulmonary adenocarcinoma with EGFR mutations, but physicians must also be aware of the side effects caused by such therapy. PMID: 29575765
- Herein we report a rare case presenting as multiple lung adenocarcinomas with four different EGFR gene mutations detected in three lung tumors. PMID: 29577613
- Study supports the involvement of EGFR, HER2 and HER3 in BCC aggressiveness of and in tumor differentiating towards different histological subtypes. PMID: 30173251
- The ratio of sFlt-1/sEGFR could be used as a novel candidate biochemical marker in monitoring the severity of preterm preeclampsia. sEndoglin and sEGFR may be involved in the pathogenesis of small for gestational age in preterm preelampsia. PMID: 30177039
- Study confirmed prognostic effect of EGFR and VEGFR2 for recurrent disease and survival rates in patients with epithelial ovarian cancer. PMID: 30066848
- The data indicate that diagnostic or therapeutic chest radiation may predispose patients with decreased stromal PTEN expression to secondary breast cancer, and that prophylactic EGFR inhibition may reduce this risk. PMID: 30018330
- suggest a unique regulatory feature of PHLDA1 to inhibit the ErbB receptor oligomerization process and thereby control the activity of receptor signaling network. PMID: 29233889
- study observed the occurrence of not only EGFR C797S mutation but also L792F/Y/H in three NSCLC clinical subjects with acquired resistance to osimertinib treatment PMID: 28093244
- Data show that the expression level of epidermal growth factor-like domain 7 (EGFL7) and epidermal growth factor receptor (EGFR) in invasive growth hormone-producing pituitary adenomas (GHPA) was much higher than that of non-invasive GHPA. PMID: 29951953
- Concurrent mutations, in genes such as CDKN2B or RB1, were associated with worse clinical outcome in lung adenocarcinoma patients with EGFR active mutations. PMID: 29343775
- ER-alpha36/EGFR signaling loop promotes growth of hepatocellular carcinoma cells PMID: 29481815
- High EGFR expression is associated with colorectal cancer. PMID: 30106444
- High EGFR expression is associated with gefitinib resistance in lung cancer. PMID: 30106446
- High EGFR expression is associated with tumor-node-metastasis in nonsmall cell lung cancer. PMID: 30106450
- Data suggest that Thr264 in TRPV3 is key ERK1 phosphorylation site mediating EGFR-induced sensitization of TRPV3 to stimulate signaling pathways involved in regulating skin homeostasis. (TRPV3 = transient receptor potential cation channel subfamily V member-3; ERK1 = extracellular signal-regulated kinase-1; EGFR = epidermal growth factor receptor) PMID: 29084846
- The EGFR mutation frequency in Middle East and African patients is higher than that shown in white populations but still lower than the frequency reported in Asian populations. PMID: 30217176
- EGFR-containing exosomes derived from cancer cells could favour the development of a liver-like microenvironment promoting liver-specific metastasis. PMID: 28393839
- The results reveal that the EGF-STAT3 signaling pathway promotes and maintains colorectal cancer (CRC)stemness. In addition, a crosstalk between STAT3 and Wnt activates the Wnt/beta-catenin signaling pathway, which is also responsible for cancer stemness. Thus, STAT3 is a putative therapeutic target for CRC treatment. PMID: 30068339
- This result indicated that T790M mutation is not only associated with EGFR-TKI resistance but also may play a functional role in the malignant progression of lung adenocarcinoma. PMID: 29887244
- LOX regulates EGFR cell surface retention to drive tumour progression. PMID: 28416796
- In a Han Chinese population, EGFR gene polymorphisms, rs730437 and rs1468727 and haplotype A-C-C were shown to be possible protective factors for the development of Alzheimer's Disease. PMID: 30026459
- EGFR proteins at different cellular locations in lung adenocarcinoma might influence the biology of cancer cells and are an independent indicator of more favorable prognosis and treatment response. PMID: 29950164
- Here we report the crystal structure of EGFR T790M/C797S/V948R in complex with EAI045, a new type of EGFR TKI that binds to EGFR reversibly and not relying on Cys 797. PMID: 29802850
- Overexpression of miR-452-3p promoted cell proliferation and mobility and suppressed apoptosis. MiR-452-3p enhanced EGFR and phosphorylated AKT (pAKT) expression but inhibited p21 expression level. MiR-452-3p promoted hepatocellular carcinoma (HCC)cell proliferation and mobility by directly targeting the CPEB3/EGFR axis PMID: 29332449
- This study shows that the D2A sequence of the UPAR induces cell growth through alphaVbeta3 integrin and EGFR. PMID: 29184982
- BRAF and EGFR inhibitors are able to synergize to increase cytotoxic effects and decrease stem cell capacities in BRAF(V600E)-mutant colorectal cancer cells PMID: 29534162
- This study confirms a direct correlation between MSI1 and EGFR and may support the important role of MSI1 in activation of EGFR through NOTCH/WNT pathways in esophageal squamous cell carcinoma. PMID: 30202417
- Three lines of tyrosine kinase inhibitors (TKIs) therapy can prolong survival in non-small cell lung cancer (NSCLC) patients. Elderly patients can benefit from TKI therapy. EGFR mutation-positive patients can benefit from second-line or third-line TKI therapy. PMID: 29266865
- EGFR 19Del and L858R mutations are good biomarkers for predicting the clinical response of EGFR-TKIs. 19Del mutations may have a better clinical outcome. PMID: 29222872
- HMGA2-EGFR constitutively induced a higher level of phosphorylated STAT5B than EGFRvIII. PMID: 29193056
顯示更多
收起更多
-
相關疾病:Lung cancer (LNCR); Inflammatory skin and bowel disease, neonatal, 2 (NISBD2)
-
亞細胞定位:Cell membrane; Single-pass type I membrane protein. Endoplasmic reticulum membrane; Single-pass type I membrane protein. Golgi apparatus membrane; Single-pass type I membrane protein. Nucleus membrane; Single-pass type I membrane protein. Endosome. Endosome membrane. Nucleus.; [Isoform 2]: Secreted.
-
蛋白家族:Protein kinase superfamily, Tyr protein kinase family, EGF receptor subfamily
-
組織特異性:Ubiquitously expressed. Isoform 2 is also expressed in ovarian cancers.
-
數據庫鏈接:
Most popular with customers
-
-
YWHAB Recombinant Monoclonal Antibody
Applications: ELISA, WB, IHC, IF, FC
Species Reactivity: Human, Mouse, Rat
-
-
-
-
-
-